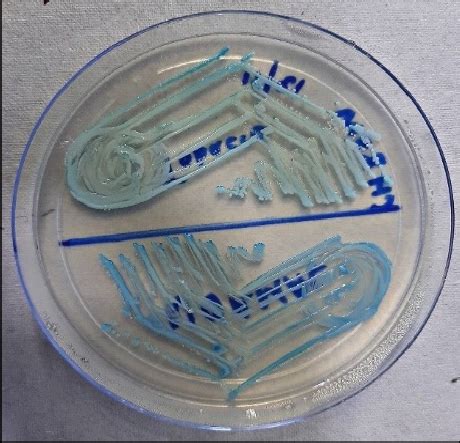
candida albicans  candida tropicalis  chromagar

If you are looking for Chromagar Candida you've come to the right place. We have 28 images about Chromagar Candida including images, pictures, photos, wallpapers, and more. In these page, we also have variety of images available. Such as png, jpg, animated gifs, pic art, logo, black and white, transparent, etc.

Not only Chromagar Candida, you could also find another pics such as
Color Chart,
Pink Growth,
Chromogenic Agar,
Agar Merck,
Colors,
Albicans,
Auris,
Remel,
HYLAB,
Krusei,
Plus 500.0 mL,
Ifu,
CHROMagar Candida Plates,
Hardy,
Brown Colonies,
Medio De Cutivo,
Auris Blue Halo,
Spherica,
Kefir,
Colony,
Medium BD,
and Aureus.
 1140×881 chromagar candida chromagar from www.chromagar.com
1140×881 chromagar candida chromagar from www.chromagar.com
 1024×1024 chromagar candida chromagar from www.chromagar.com
1024×1024 chromagar candida chromagar from www.chromagar.com
 600×600 chromagar candida highly recommended medium isolation from ghanamedicals.com
600×600 chromagar candida highly recommended medium isolation from ghanamedicals.com
 1920×1370 chromagar widest range chromogenic media from www.chromagar.com
1920×1370 chromagar widest range chromogenic media from www.chromagar.com
 1500×1225 chromagar candida images stock objects vectors from www.shutterstock.com
1500×1225 chromagar candida images stock objects vectors from www.shutterstock.com
 436×600 chromagar candida drg international from store.drg-international.com
436×600 chromagar candida drg international from store.drg-international.com
 1024×576 candida chromagar introduction archives medical notes from medicallabnotes.com
1024×576 candida chromagar introduction archives medical notes from medicallabnotes.com
 850×638 candida albicans grown chromagar candida scientific from www.researchgate.net
850×638 candida albicans grown chromagar candida scientific from www.researchgate.net
 1500×1225 candida albicans grow chromagar candida stock photo from www.shutterstock.com
1500×1225 candida albicans grow chromagar candida stock photo from www.shutterstock.com
 568×473 yeasts genus candida chromagar candida candida albicans from www.researchgate.net
568×473 yeasts genus candida chromagar candida candida albicans from www.researchgate.net
 460×443 candida albicans candida tropicalis chromagar from www.researchgate.net
460×443 candida albicans candida tropicalis chromagar from www.researchgate.net
 535×546 candida colonies chromagar tobacco user group from www.researchgate.net
535×546 candida colonies chromagar tobacco user group from www.researchgate.net
 1000×1000 chromagar candida microbac from microbacsa.com
1000×1000 chromagar candida microbac from microbacsa.com
 3024×4032 chromagar reddit post comment search socialgrep from socialgrep.com
3024×4032 chromagar reddit post comment search socialgrep from socialgrep.com
 547×737 utility chromagar candida presumptive identification from www.academia.edu
547×737 utility chromagar candida presumptive identification from www.academia.edu
 320×320 colors candida species chromagar candida chromogenic from www.researchgate.net
320×320 colors candida species chromagar candida chromogenic from www.researchgate.net
 640×640 candida isolates grown chromagar albicans control from www.researchgate.net
640×640 candida isolates grown chromagar albicans control from www.researchgate.net
 850×853 strain morphology chromagar candida sabouraud from www.researchgate.net
850×853 strain morphology chromagar candida sabouraud from www.researchgate.net
 850×732 ab colonies grown chromagar candida front from www.researchgate.net
850×732 ab colonies grown chromagar candida front from www.researchgate.net
 1600×1300 chromagar candida xmm plastlabor from plastlabor.com.br
1600×1300 chromagar candida xmm plastlabor from plastlabor.com.br
 726×1024 chromagar candida gali spol ro from www.gali.cz
726×1024 chromagar candida gali spol ro from www.gali.cz
 1290×1290 chromagar candida sano distribution from sanodistribution.com
1290×1290 chromagar candida sano distribution from sanodistribution.com
 682×350 chromagar candida interlab from www.interlabdist.com.br
682×350 chromagar candida interlab from www.interlabdist.com.br
 800×800 chromagar candida from www.proventa.com.mx
800×800 chromagar candida from www.proventa.com.mx
600×600 candida chromagar analytichem from biotrading.com
600×600 candida chromagar analytichem from biotrading.com
 800×800 chromagar microbiology linkedin candidaauris fungalinfections from www.linkedin.com
800×800 chromagar microbiology linkedin candidaauris fungalinfections from www.linkedin.com
 600×600 chromagar from www.kanto.co.jp
600×600 chromagar from www.kanto.co.jp
 1280×720 candida colony from ar.inspiredpencil.com
1280×720 candida colony from ar.inspiredpencil.com
Don't forget to bookmark Chromagar Candida using Ctrl + D (PC) or Command + D (macos). If you are using mobile phone, you could also use menu drawer from browser. Whether it's Windows, Mac, iOs or Android, you will be able to download the images using download button.